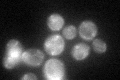
YOR241W
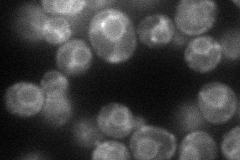
YOR241W
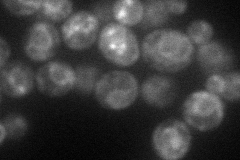
YOR241W
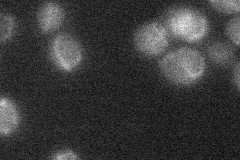
YOR241W
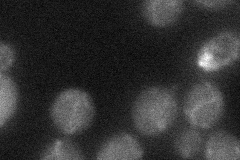
YOR241W
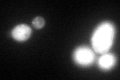
YOR241W

View description
Folylpolyglutamate synthetase, catalyzes extension of the glutamate chains of the folate coenzymes, required for methionine synthesis and for maintenance of mitochondrial DNA
Localization:
Intensity:
Fold change:
Significance:
-
C’ GFP library in SD
punctate:cytosol64.21 -
N' NOP1pr-GFP in SD
ER53.0456 -
N' TEF2pr-mCherry in SD
ER54.4678 -
N' NATIVEpr-GFP in SD
below threshold11.7755 -
N' TEF2pr-VC and Cyto-VN in SD
below threshold26.7141 -
C’ GFP library in SD+DTT
punctate.cytosol67.351.04No -
C’ GFP library in SD+H2O2

punctate.cytosol65.721.02No -
C’ GFP library in Starvation Media

punctate,cytosol68.631.06No -
C’ GFP library on the background of Pup2-DaMP

punctate:cytosol -
C’ GFP library on the background of CCT mutant

punctate:cytosol67.87871.05701No
